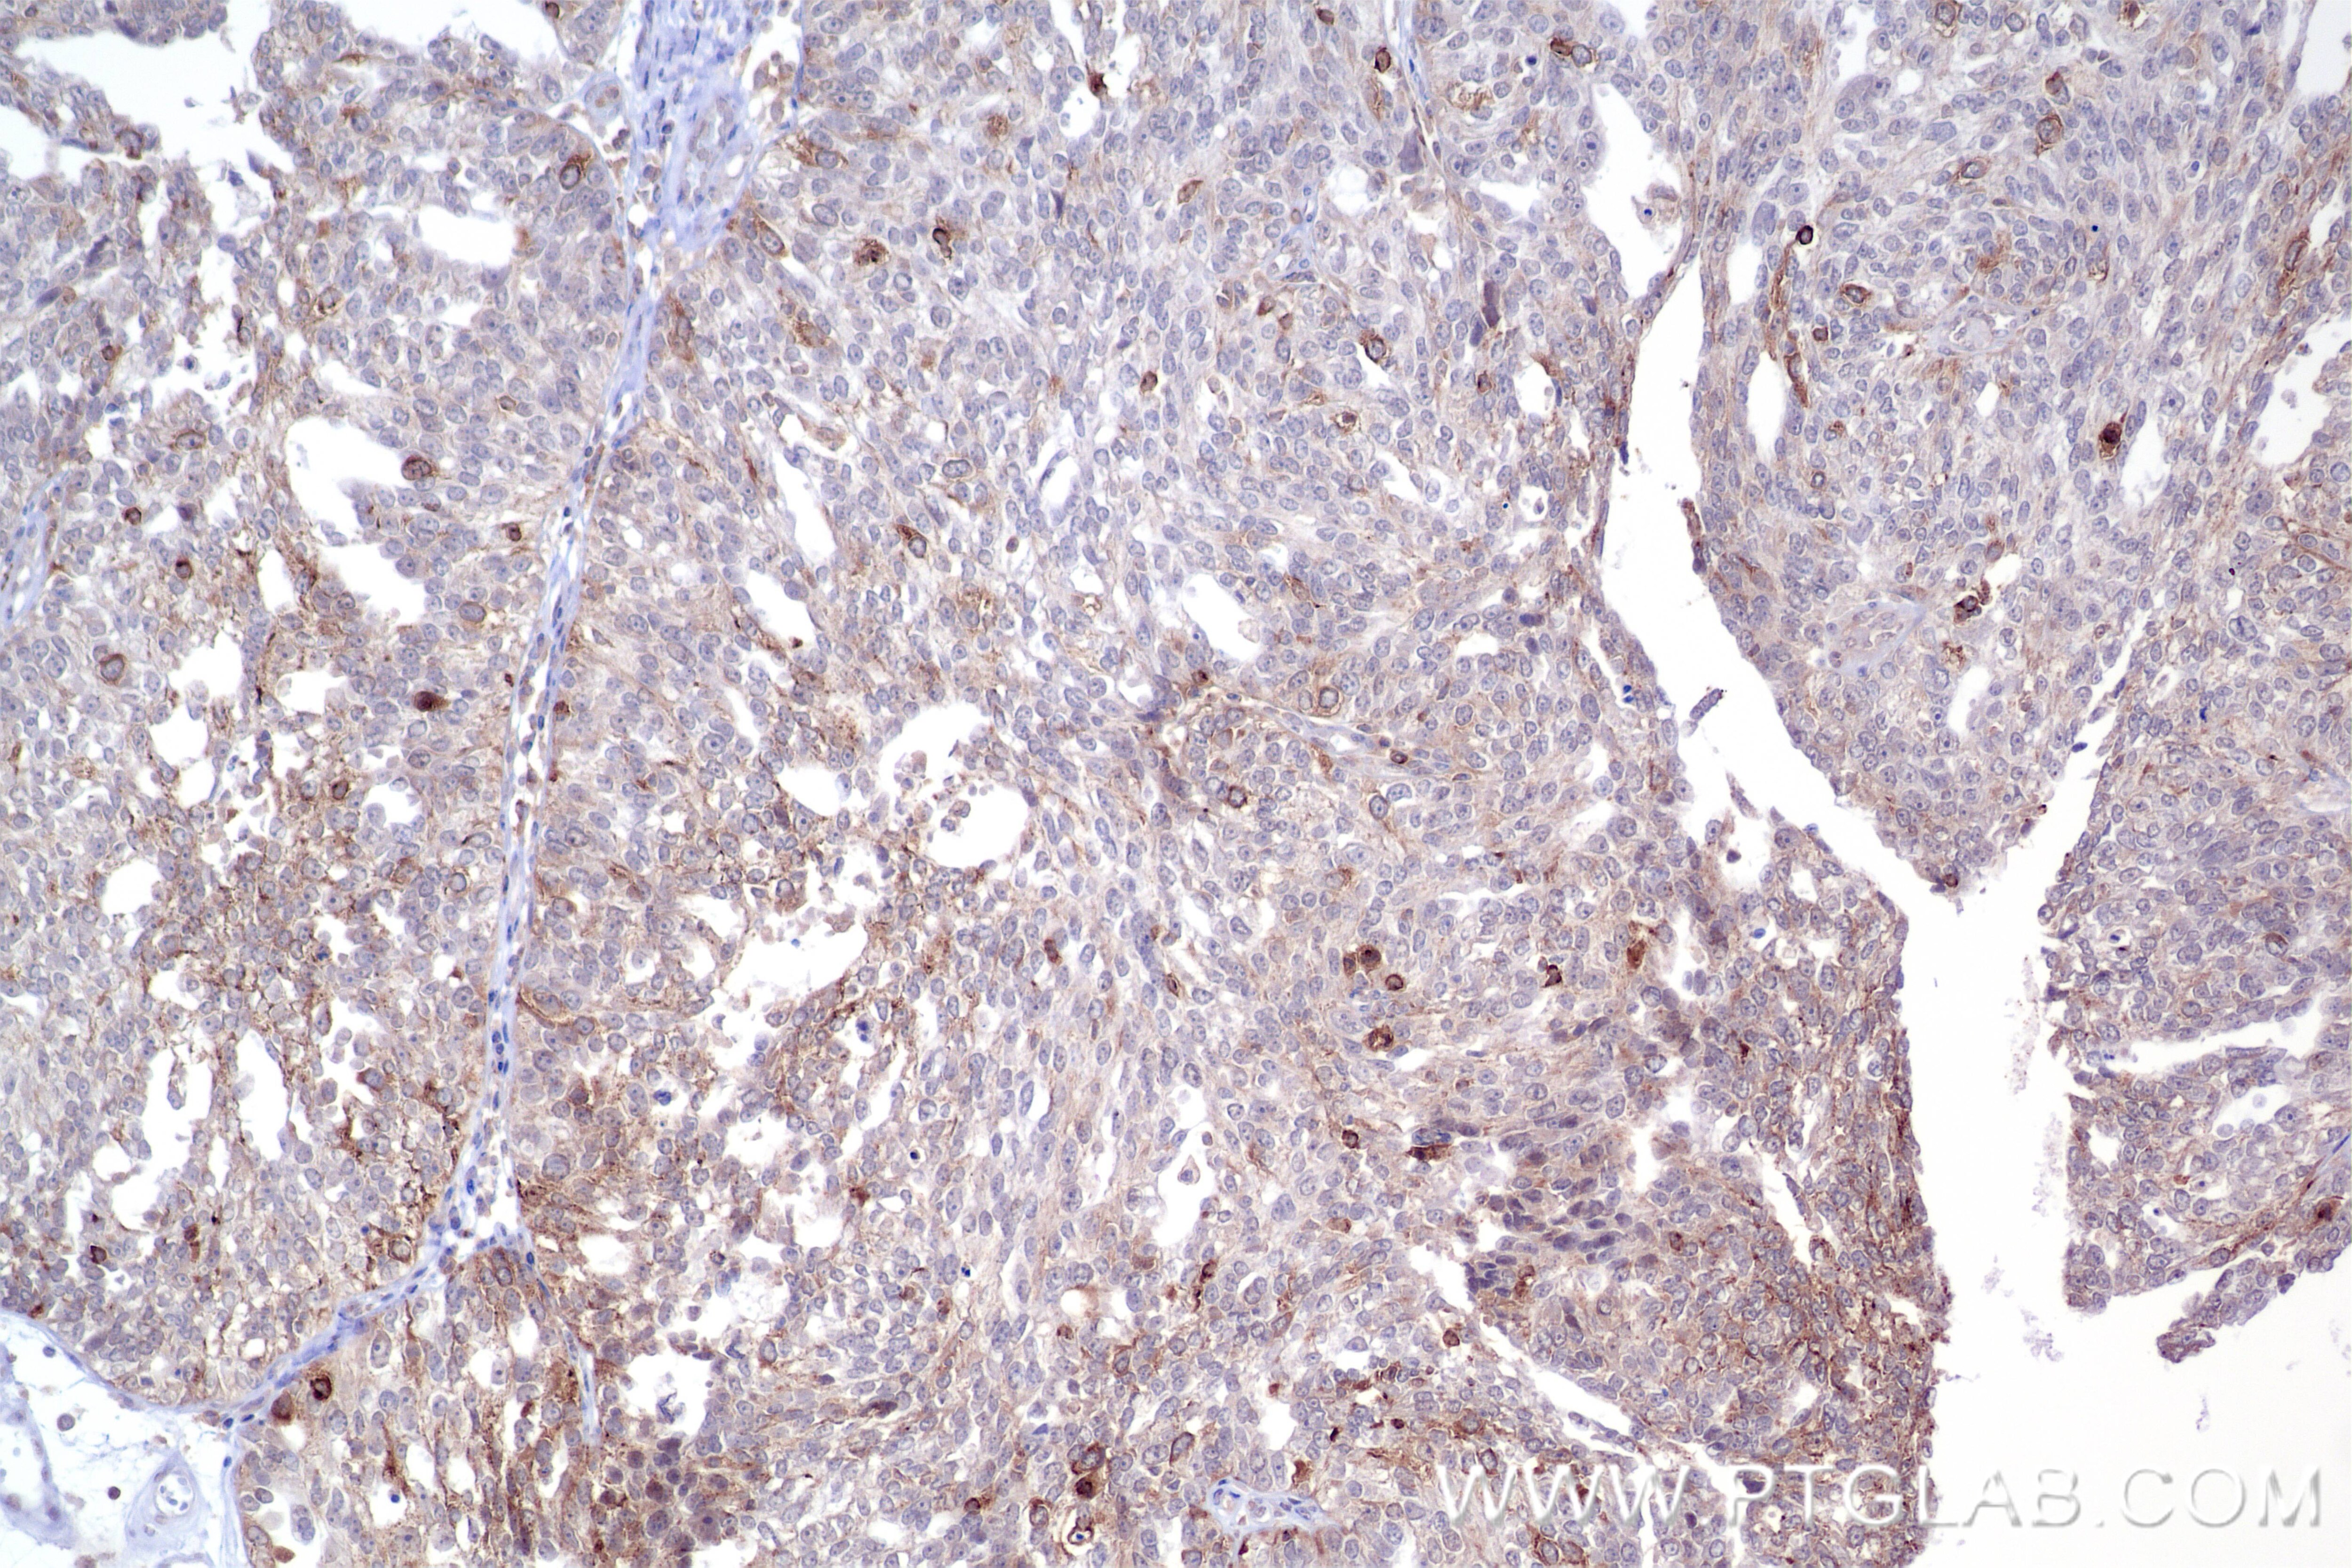
Immunohistochemical analysis of paraffin-embedded human ovary cancer tissue slide using 84940-5-RR (TACC3 antibody) at dilution of 1:500 (under 10x lens). Heat mediated antigen retrieval with Tris-EDTA buffer (pH 9.0). Immunohistochemistry (IHC) staining of human ovary cancer tissue using TACC3 Recombinant antibody (84940-5-RR)

Validation Data Gallery
Tested Applications
| Positive WB detected in | HeLa cells, SKOV-3 cells, Caco-2 cells |
| Positive IHC detected in | human ovary cancer tissue Note: suggested antigen retrieval with TE buffer pH 9.0; (*) Alternatively, antigen retrieval may be performed with citrate buffer pH 6.0 |
| Positive IF/ICC detected in | HeLa cells |
Recommended dilution
| Application | Dilution |
|---|---|
| Western Blot (WB) | WB : 1:5000-1:50000 |
| Immunohistochemistry (IHC) | IHC : 1:250-1:1000 |
| Immunofluorescence (IF)/ICC | IF/ICC : 1:200-1:800 |
| It is recommended that this reagent should be titrated in each testing system to obtain optimal results. | |
| Sample-dependent, Check data in validation data gallery. | |
Product Information
84940-5-RR targets TACC3 in WB, IHC, IF/ICC, ELISA applications and shows reactivity with human samples.
| Tested Reactivity | human |
| Host / Isotype | Rabbit / IgG |
| Class | Recombinant |
| Type | Antibody |
| Immunogen |
CatNo: Ag22516 Product name: Recombinant human TACC3 protein Source: e coli.-derived, PGEX-4T Tag: GST Domain: 141-330 aa of BC111771 Sequence: SSESGPGALADLDCSSSSQSPGSSENQMVSPGKVSGSPEQAVEENLSSYSLDRRVTPASETLEDPCRTESQHKAETPHGAEEECKAETPHGAEEECRHGGVCAPAAVATSPPGAIPKEACGGAPLQGLPGEALGYPAGVGTPVPADSTQTLTCAHTSAPESTAPTNHLVAGRAMTLSPQEEVAAGQMASS 相同性解析による交差性が予測される生物種 |
| Full Name | transforming, acidic coiled-coil containing protein 3 |
| Calculated molecular weight | 838 aa, 91 kDa |
| Observed molecular weight | 160 kDa |
| GenBank accession number | BC111771 |
| Gene Symbol | TACC3 |
| Gene ID (NCBI) | 10460 |
| Conjugate | Unconjugated |
| Form | |
| Form | Liquid |
| Purification Method | Protein A purfication |
| UNIPROT ID | Q9Y6A5 |
| Storage Buffer | PBS with 0.02% sodium azide and 50% glycerol{{ptg:BufferTemp}}7.3 |
| Storage Conditions | Store at -20°C. Stable for one year after shipment. Aliquoting is unnecessary for -20oC storage. |
Background Information
TACC3, also known as ERIC 1, belongs to the TACC family. TACC family members TACC1, TACC2, and TACC3 map very closely to the corresponding FGFR1, FGFR2, FGFR3 genes on chromosomes 8, 10, and 4. Subsequently, since they are phylogenetically related, it is proposed that TACC and FGFR have similar roles in cell growth and differentiation. It plays a role in the microtubule-dependent coupling of the nucleus and the centrosome and involved in the processes that regulate centrosome-mediated interkinetic nuclear migration (INM) of neural progenitors.
Protocols
| Product Specific Protocols | |
|---|---|
| IHC protocol for TACC3 antibody 84940-5-RR | Download protocol |
| WB protocol for TACC3 antibody 84940-5-RR | Download protocol |
| Standard Protocols | |
|---|---|
| Click here to view our Standard Protocols |